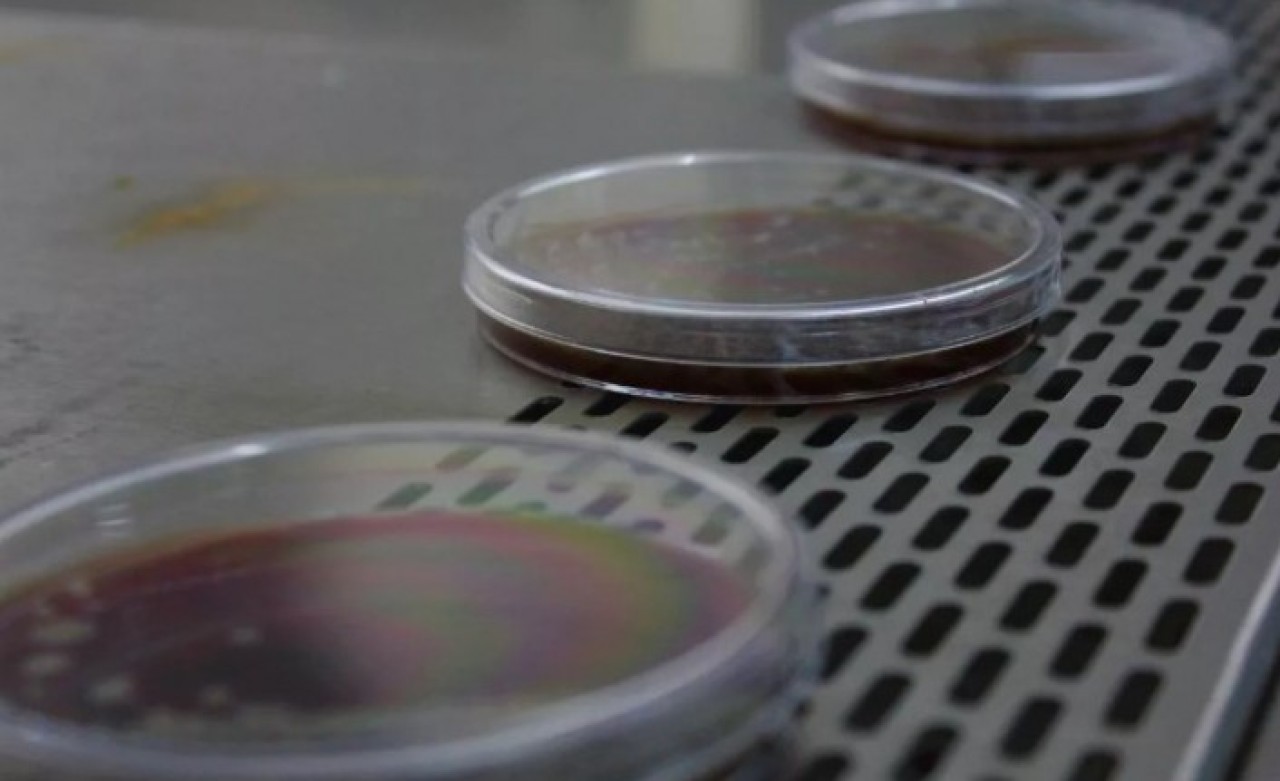
Maskelerdeki incelemelerde korkutan sonuç! Bunu yapıyorsanız dikkat

Türkiye’de aşılama süreci başlamış olsa da maskeler bir süre daha virüse karşı en etkili yöntemlerden biri olarak kullanıyor. Samsun Ondokuz Mayıs Üniversitesi (OMÜ) Mikrobiyoloji Laboratuvarı tarafından, kullanıldıktan sonra kolonya sıkılmış veya yıkanmış maskeler incelendi.
İncelemede, kullanılan tıbbi maskelere kolonya sıkmanın veya yıkamanın bakteri oluşumunu engelleyecek bir etki yapmadığı belirlendi.
YANLIŞ KULLANIM TEHLİKE SAÇIYOR
Koronavirüs pandemi sürecinde maske kullanımın ne kadar önemli olduğu bütün bilim camiası tarafından kabul edildi. Doğru kullanıldığı takdirde virüsten koruyan maskeler yanlış kullanıldığı zaman tehlike saçıyor. OMÜ Mikrobiyoloji Anabilim Dalında görevli akademisyenler tarafından yapılan testte, tıbbı maskelere kolonya sıkmak veya yıkamanın bakteri oluşumunu engelleyici bir etkisi olmadığı laboratuvar ortamında gözlemlendi.
1 gün kullanılmış normal maske, kolonya sıkılmış maske ve yıkanmış maskelerin bakteri yoğunluğuna bakıldığı zaman aralarında neredeyse fark olmamasının endişe uyandırıcı olduğu gözler önüne serildi.
ÖNEMLİ UYARI
Maskelerin üzerine kolonya veya herhangi bir anti-septik uygulandıktan sonra kullanılmasının bakteri oluşumunu engellemediğini belirten OMÜ Mikrobiyoloji Anabilim Dalı Öğretim Üyesi Doç. Dr. Yeliz Tanrıverdi Çaycı, “Duyuyoruz ki insanlar maskeleri tekrar kullanabilmek için çeşitli işlemler uyguluyorlar. Bunlardan bir tanesi de kolonya dökmek olduğunu duyduk. Maskelere kolonya döküldüğü zaman maalesef ki oradaki mikroorganizmaları elimine edemiyorsunuz. Dezenfektanlar ve antiseptik maddeler kullanılması öncesi bir temizlik gerekir, sonrasında uygulayabilirsiniz. Biz yaptığımız çalışmada gördük ki maskenin üzerine kolonya döktükten bir süre sonra örnek aldığımız zaman bakteriler yoğun bir şekilde üreyebilmekte. Bu nedenle maskelerinize kolonya veya herhangi bir antiseptik madde döküp sonrasında kullanmayın. Bu maskeler tek kullanım için uygundur. Islandığı, nemlendiği veya kirlendiğini düşündüğünüz zaman lütfen yenisi ile değiştirin” dedi.
"TIBBİ MASKELER YIKANMAYA UYGUN DEĞİL"
Tıbbı maskelerin yıkanmaya uygun olmadığı ve tekrar tekrar kullanılmaması gerektiğine dikkat çeken Doç. Dr. Çaycı, “Tıbbı maskeler yıkanmaya uygun maskeler değildir. Bunları yıkayarak hem temizleyemezsiniz hem de etkinliklerini azaltmış olursunuz. Maskenin yapısı bozulduğu için koruyuculuğu azalır. Maskeleri tekrar tekrar yıkayıp kullanmayalım. Yıkandığı zaman bile mikroorganizmalar maskenin üzerinde rahatça üreyebilmekte. Herkesin maske kullanımından sıkıldığını biliyoruz ama şu an korona virüs etkinliğine karşı yapabileceğiz tek şey maske, mesafe ve hijyen kurallarına uymaktır. Maskelerimiz kirlendiği, ıslandığı ve nemlendiği zaman yenisi ile değiştirelim” diye konuştu.